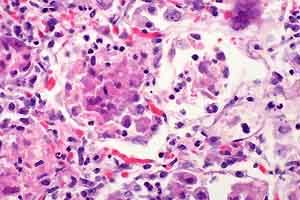

Results
AFIP Wednesday Slide Conference - No. 30
May 17, 2000
- Conference Moderator:
LTC Thomas P. Lipscomb
Division of Veterinary Pathology
Armed Forces Institute of Pathology
Washington DC 20306-6000
- Return to WSC Case Menu
-
- Case I - 98C10269-53, 54, 55, or 56 (AFIP 2679490)
-
- Signalment: 2-year-old, castrated, 29-kg husky-German
shepherd crossbred dog.
-
- History: The dog developed sensory ataxia and conscious
proprioceptive deficits in all limbs. The clinical course began
abruptly with lameness of the left pelvic limb. The dog walked
with a distinctive uncoordinated stumbling gait. Neurological
examination revealed loss of proprioceptive and patellar reflexes.
Cranial nerves and deep pain reflexes were clinically normal,
megaesophagus was absent, and clinical signs were constant.
The dog was referred to a veterinary teaching hospital where
the tentative diagnosis was diffuse lower motor neuron disease.
-
- Serological test results were "consistent with myasthenia
gravis." The dog was treated without improvement with pyridostigmine
bromide syrup (Mestinon®). Two attempts were made to corroborate
the diagnosis of myasthenia gravis using a short- and rapid-acting
cholinergic compound (edrophonium chloride; Tensilon® test).
On both occasions the dog's status failed to improve and the
clinician concluded the serological finding indicating myasthenia
gravis was unrelated to sensory ataxia. The animal's condition
continued to deteriorate, in spite of transient remission of
some clinical signs. The dog was euthanized after a clinical
course of four months.
-

- Case 30-1. Spinal cord, dura. There is a pale white
discoloration affecting gray and white matter of the dorsal funiculi.
-
- Gross Pathology: Necropsy revealed a 32.5-kg dog in
good flesh. There was no gross evidence of muscular atrophy.
A V-shaped area of marked pallor involved dorsal columns at all
levels of the spinal cord.
-
- Laboratory Results: Immunoprecipitation radioimmunoassay
for AChR antibodies: 2A3 nmol/L. (Reference range in healthy
dogs: <0.6 nmol/L)
-
- Contributor's Diagnosis and Comments: Axonal (Wallerian)
degeneration, severe, diffuse, chronic, bilaterally symmetrical,
dorsal columns and dorsal spinal nerve roots, with associated
mild chronic lymphocytic-histiocytic myelitis and neuritis.
-
- The other major change in this dog was multifocal lymphocytic-histiocytic
ganglioneuritis of spinal ganglia with neuronal loss and Nageotte
nodules. Other lesions were the presence of uncharacterized,
PAS-negative spherical inclusions in neurohypophysis, supraoptic
hypothalamus and ventromedial periventricular thalamic nuclei;
axonal degeneration restricted to selected fascicles in radial
and ulnar nerves; moderate diffuse skeletal muscular atrophy
in M flexor carpi ulnaris; and mild ganglioneuritis in an unidentified
ganglion adjacent to adrenal gland. In addition to the submitted
levels of spinal cord, some of the submitted blocks include levels
of thalamus and medulla oblongata. Unfortunately the thalamic
inclusions are highly localized and are not present in most of
the submitted slides.
-
- Clinical signs and lesions were consistent with a diagnosis
of sensory neuropathy. The condition has various sobriquets
in addition to sensory neuropathy: sensory neuronopathy, chronic
idiopathic polyneuritis, and ganglioradiculitis. Degeneration
in sensory tracts in dorsal columns is attributable to loss of
somata in dorsal root ganglia. The prognosis in the disease
is poor. In this case, there was no consistent response to immunosuppression
with corticosteroids. The waxing and waning course, which is
typical of some cases of this disease, makes it hard to assess
the effectiveness of medications used to slow clinical progression.
-
- In this case no attempt was made to isolate infectious agents,
including viruses. Nothing in the animal's history indicated
recent exposure to toxic compounds, including medications. Huskies
are over-represented in case reports and it may be significant
the dog was part husky. The submitting veterinarian was unable
to obtain a history about the fate of this dog's littermates.
Summers et al speculate this disease is an autoimmune T-lymphocyte
mediated reaction directed against spinal ganglia, and note its
similarity to Sjögren's syndrome in people. I was unsure
of the significance of positive results indicating myasthenia
gravis, an autoimmune disease that leads to loss of acetylcholine
receptors in neuromuscular junctions. Clinical signs and response
to treatment were inconsistent with generalized myasthenia gravis.
A recent large-scale retrospective study of acquired myasthenia
gravis in dogs did not report an association with sensory neuropathy,
and it has not been noted in case reports of this disease.
-
- AFIP Diagnoses:
- 1. Spinal cord, dorsal columns: Axonal (Wallerian) degeneration,
diffuse, severe, with numerous gitter cells, mild lymphocytic
meningomyelitis and mild astrocytosis, husky X German shepherd
dog cross, canine.
2. Dorsal spinal nerve roots: Axonal (Wallerian) degeneration,
diffuse, severe, with Schwann cell proliferation, gitter cells
and mild lymphocytic neuritis.
-
- Conference Note: Conference participants agreed that
the lesions suggested sensory neuropathy. Much of the discussion
centered on Wallerian degeneration. Classically, Wallerian degeneration
includes the changes that take place in the distal segment of
a transected axon in the peripheral nervous system. There are
significant differences between axonal injury in the peripheral
and central nervous systems. Thus, some refer to similar changes
in the CNS as Wallerian-type degeneration. In either location,
the process basically consists of the breakdown and removal of
the distal axon and the myelin tube.
-
- Differences in axonal repair have major clinical significance.
In the PNS, axonal sprouts growing from the stump of the proximal
axon are guided by the preexisting basal lamina into a newly
formed column of Schwann cells. In the CNS, there is no basal
lamina and oligodendrocytes don't form columns to guide reinnervation.
Additionally, oligodendrocyte myelin proteins inhibit axonal
sprouting. Thus, CNS axonal repair is much less effective than
that in the PNS.
-
- Contributor: Wyoming State Veterinary Laboratory,
1174 Snowy Range Road, Laramie, WY 82070.
-
- References:
- 1. Shelton GD, Schule A, Kass PH: Risk factors for acquired
myasthenia gravis in dogs: 1,154 cases (1991-1995). J Am Vet
Med Assoc 211(11):1428-31, 1997
- 2. Summers BA, Cummings YF, de Lahunta A: Veterinary Neuropathology,
pp. 428-431. Mosby-Year Book Inc., Baltimore, MD, 1995
-
-
- Case II - HB2418 (AFIP 2602959)
-
- Signalment: A nine-year-old female mixed breed dog.
-
- History: This dog had large subcutaneous mass, located
on the right side of the body, close to the diaphragm. Initially,
a needle biopsy was performed, but the specimen was inadequate
for diagnosis. Then the mass was incompletely resected surgically.
-
- Gross Pathology: This large mass, 8.8 x 7.9 x 7.4
cm, was not associated with bone (by X-ray). It was adhered
to diaphragm, pink and granular on cut surface.
-
- Contributor's Diagnosis and Comments: The neoplastic
cells are arranged in solid sheets. The cells vary in size,
have eosinophilic cytoplasm, are round to polyhedral, and are
highly pleomorphic. The cells have large vesicular round to
ovoid nuclei that contain one or more prominent, irregular-shaped
nucleoli. Other characteristic features include vacuolated cells,
moderate fibroplasia, osteoclast--like giant cells, and giant
cells containing a single large nucleus. Mitotic figures were
frequently seen.
-
- The neoplasm was diagnosed as rhabdomyosarcoma (pleomorphic
type), originating from rhabdomyoblasts. Although special staining
revealed intracellular glycogen (PAS positive), striations were
not seen after phosphotungstic acid hematoxylin (PTAH) staining.
Immunohistochemical procedures demonstrated the presence of
desmin, vimentin and myoglobin type of intermediate filaments
in the neoplastic cells.
-
- Rhabdomyosarcomas vary widely in histological appearance,
depending on the growth pattern, cellularity, degree of differentiation,
and configuration of the individual tumor cells. These tumors
are usually highly malignant and metastasize either via the lymphatic
or venous routes. Metastatic sites include lymph nodes, lung,
spleen, heart and skeletal muscle.
- In humans, this neoplasm is the most frequent soft tissue
tumor in children but is uncommon in adults. Numerous reports
have documented the occurrence of rhabdo-myosarcomas in the head
and neck, the genitourinary tract and retrope-ritoneum, and the
upper and lower extremities.
-
- The age distribution is not as well documented in domestic
animals, but the tumor is considered to be more frequent in younger
animals. The three major types are alveolar, embryonal, and
pleomorphic. Although osteoclast--like giant cells are prominent
in this case, the most useful diagnostic charac-teristic of tumor
cells in embryonal and pleomorphic types of rhabdomyosarcoma
is the irregular angularity of the cells, including an extreme
range m the size of the nuclei.
-
- AFIP Diagnosis: Skeletal muscle: Pleomorphic rhabdomyosarcoma,
mixed breed, canine.
-
- Conference Note: Among animals, rhabdomyosarcomas
are most often encountered in dogs. Pleomorphic and embryonal
types are described. Most of the embryonal types have been found
in the urinary bladders of young, large breed dogs. The diagnostic
criteria for rhabdomyosarcoma have changed over time. When cross-striations
were required for diagnosis, the tumors were very rare. With
the advent of immunohistochemistry, diagnosis rests on compatible
histomorphology combined with positive staining for muscle markers
such as desmin, myoglobin and muscle specific actin (HHF35).
The main diagnostic problem is distinguishing rhabdomyosarcoma
from other pleomorphic sarcomas, principally malignant fibrous
histiocytoma.
-
- In the absence of cross striations, the most specific histomorphologic
feature of rhabdomyosarcoma is the presence of rhabdomyoblasts.
These cells range from slender spindle-shaped cells with a small
number of peripherally placed myofibrils, to large, eosinophilic
cells with a strap, ribbon, tadpole or racquet shape and one
or two central nuclei and prominent nucleoli. Rhabdomyoblasts
often appear as round, eosinophilic cells in which the nucleus
is surrounded by filamentous stringy material. Cells with similar
morphology and multiple peripheral cytoplasmic vacuoles (so called
"spiderweb" cells) are also highly characteristic.
Good examples of rhabdomyoblasts and spiderweb cells are present
in this case.
-
- Contributor: Laboratory of Comparative Pathology,
Graduate School of Veterinary Medicine, Hokkaido University,
Sapporo 060, Japan.
-
- References:
- 1. Enzinger FM, Weiss SW: Soft Tissue Tumors, 2nd ed, pp.448-488.
Mosby, ST. Louis, MO, 1988
- 2. Hulland TJ: Tumors of the muscle. In: Tumors in Domestic
Animals, ed. Moulton JE, pp.88-101. University of California
Press, Berkeley, CA. 1990
- 3. Martin de las Mulas I, Vos JH, Van Mil FN: Desmin and
vimentin immunocha-racterization of feline muscle tumor. Vet
Pathol 29:260-262, 1992
-
-
- Case III - 99-19676 (AFIP 2675234)
-
- Signalment: 23-month-old, intact male, Italian greyhound
-
- History: Acute onset of anorexia followed by seizures
of 1-2 days duration. The dog presented to the referring veterinarian
stuporous with extreme neck pain. Analysis of cerebrospinal
fluid revealed a marked pleocytosis and numerous fungal organisms
(morphologically consistent with Cryptococcus). Ophthalmologic
examination showed papilledema. The owners elected euthanasia.
-
- Gross Pathology: Small quantities of exudate were
noted in the left nasal passage and right retrobulbar space.
The cerebrospinal fluid contained white flocculent material.
The brain was grossly unremarkable prior to formalin fixation.
Following adequate fixation, the meninges covering virtually
all of the brain and brainstem were faintly cloudy to opaque.
Also noted was megaesophagus of the intrathoracic esophagus.
-
- Contributor's Diagnosis and Comments: Severe, chronic,
diffuse granulomatous meningitis with numerous intralesional
yeasts (Cryptococcus) and rare multinucleated giant cells.
-
- Although several different species exist, Cryptococcus neoformans
is primarily responsible for disease in animals and man. Two
variants (neoformans and gattii) and five serotypes (A, B, C,
D, AD) of C. neoformans have been identified to date. In the
environment, the chief reservoir of C. neoformans is avian excrement
(particularly pigeon excreta). The organism is also found in
the soil, grass and milk. Barring direct sunlight or desiccation,
organisms may remain viable in pigeon droppings for at least
2 years. The primary route of infection appears to be inhalation
of unencapsulated organisms within the environment. Following
colonization of the respiratory tract, cryptococci regenerate
their capsules. Infection of the CNS may result from hematogenous
spread or local extension from the nasal cavity.
-
- While this case does not pose a diagnostic challenge, it
does raise questions regarding the pathogenesis of this disease,
specifically: Why is there such a massive proliferation of organisms,
yet a minimal inflammatory response by the host? Why is there
such variation in inflammatory responses between infected individuals?
-
- Factors governing the establishment and spread of infection
include the virulence of the invading species and the status
of the host's immune system. The cryptococcal capsule may be
absent to small during the initial phases of infection (as in
organisms isolated from the environment). In general, as in
this case, organisms recovered from cerebrospinal fluid are heavily
encapsulated. Many strains of C. neoformans are covered
by a thick polysaccharide capsule (up to 35 microns thick) which
serves as a diagnostic hallmark of cryptococcosis.
-
- It is well established that the capsule is a prominent virulence
factor and possesses antiphagocytic and tolerogenic properties.
While most strains are heavily encapsulated, an acapsular strain
has been described in a dog with cryptococcal lymphadenitis.
In that dog, the infection was characterized by the presence
of many intracellular (within macrophages) organisms and intense
granulomatous inflammation. In addition to inhibition of phagocytosis,
the capsule suppresses cellular and humoral immunity.
-
- Capsular antigens may also suppress cytokine production.
Purified capsular polysaccharide has been shown to inhibit TNF-a
secretion induced by LPS in human monocytes. Acapsular strains
of C. neoformans stimulate higher levels of cytokine production
than do thinly encapsulated strains. In contrast, organisms
with thick capsules are poor inducers of TNF production. Recently,
an acapsular strain of C. neoformans was shown to induce
higher levels of CD4, a T cell associated transmembrane glycoprotein,
than encapsulated strains on human monocytes.
-
- The exact contribution of the host's immune system is not
clearly known in dogs. In humans, most cases (up to 85%) of
cryptococcal meningitis have an underlying condition, which is
inhibitory to the function and/or number of lymphocytes. Such
conditions include immunosuppressive therapy (glucocorticoids,
chemotherapeutics, or other agents), lymphoid tumors, diabetes
mellitus, tuberculosis or AIDS. Five to 10% of all patients
with AIDS are reported to develop cryptococcosis. While immunosuppressive
disease or the use of immunosuppressive agents has been associated
with cryptococcosis in dogs, one study could identify underlying
immunosuppressive factors in less than 6% of affected dogs.
-
- Most dogs with cryptococcosis are young adults with the average
age of 3.5 years. The dog in the present case was slightly less
than 2 years of age. Histopathology confirmed the presence of
Cryptococcus in the nasal cavity and retrobulbar region (forming
a dense cuff around the optic nerve and causing the papilledema
noted clinically). In light of these findings, a direct extension
from a rhinosinusitis is the presumptive source of the CNS infection.
-
- AFIP Diagnosis: Cerebellum: Meningitis, granulomatous,
multifocal, moderate, with numerous yeasts, Italian greyhound,
canine, etiology consistent with Cryptococcus sp.
-
- Conference Note: Cryptococcosis is the most common
systemic fungal infection of cats. The nasal cavity is affected
in over 80% of cases, and typical signs are those of upper respiratory
tract disease. Often, a firm swelling over the bridge of the
nose is evident. Skin lesions are also common and generally
result from systemic dissemination.
-
- In humans, cryptococcal infection of the CNS is associated
with increased intracranial pressure. The pathogenesis is uncertain,
but increased CSF osmolality caused by the presence of high molecular
weight cryptococcal polysaccharide and the production of D-mannitol
by the fungus are possible contributing factors.
-
- Contributor: University of Illinois, 2001 S. Lincoln
Ave, Urbana, IL 61801.
-
- References:
- 1. Jacobs GJ, Medleau L: Cryptococcosis. In Infectious
Diseases of the Dog and Cat, ed. Greene CE, pp 383-390. WB Saunders
Company, Philadelphia, PA, 1998
- 2. Lichtensteiger CA, Hilf LE: Atypical cryptococcal lymphadenitis
in a dog. Vet Pathol 31:493-496, 1994
- 3. Pietrella D, Monari C, Retini C, Palazzetti B, Kozel
TR, Vecchiarelli A: Cryptococcus neoformans and Candida albicans
regulate CD4 expression on human monocytes. J Infect Dis 178:1464-1471,
1998
- 4. Vecchiarelli A, Retini C, Pietrella D, Monari C, Tascini
C, Beccari T, Kozel TR: Downregulation by cryptococcal polysaccharide
of tumor necrosis factor alpha and interleukin-1ß secretion
from human monocytes. Infect and Immun 63:2919-2923, 1995
-
-
- Case IV - 96-1273 (AFIP 2593977)
-
- Signalment: 15-week-old, 3.4 kilogram, male dog (toy
poodle)
-
- History: The dog was initially vaccinated by the breeder
and then two weeks later by the referring veterinarian with DHLP-P.
One day after the second vaccination the dog developed corneal
edema. A veterinary ophthalmologist performed a conjunctival
flap for a bulla which developed on the right eye. The dog was
treated postoperatively with topical and systemic corticosteroids.
Three weeks after the second vaccination the dog developed a
non-productive cough with increased abdominal effort. A few
days later the dog had difficulty breathing and became cyanotic.
A severe interstitial pulmonary pattern was present on thoracic
radiographs. The dog was euthanized due to poor prognosis.
-
- Gross Pathology: The lungs were deep red and heavy
(edema) and had multiple, locally extensive, irregularly shaped
white regions (approximately 2 - 5 mm) randomly distributed throughout
all of the lobes. The liver was mottled tan and red on the capsular
and cut surfaces of all of the lobes. Bilaterally the corneas
were light blue (corneal edema).
-
- Laboratory Results:
- Canine arterial blood gas:
|
Test |
Result |
Expected |
Units |
|
pH |
7.324 |
7.370 - 7.510 |
|
|
pCO2 |
21.0 |
21.5 - 35.5 |
MM/HG |
|
pO2 |
36 |
85 - 100 |
MM/HG |
|
Bicarb |
11.0 |
15.5 - 23.5 |
MMOL/L |
|
TCO2 |
11.7 |
|
MMOL/L |
|
Base excess |
-11.9 |
-2.0 - 2.0 |
|
-
- Immunohistochemistry:
Anti-Toxoplasma gondii antibody:
Structures morphologically consistent with Toxoplasma gondii
stain.
-
- Contributor's Diagnosis and Comments: Lung: Interstitial
pneumonia, severe, diffuse, with multifocal to locally extensive
necrosis, intralesional protozoal organisms, and rare intracytoplasmic
viral inclusion bodies.
-
- Etiologies:
Toxoplasma gondii and canine distemper virus (CDV).
-
- In addition to the pulmonary lesions observed on the slide
submitted, clinically significant lesions were observed in the
liver (severe hepatic necrosis with intralesional protozoal organisms)
and brain (encephalitis with intralesional protozoal organisms
and intracytoplasmic viral inclusion bodies). Viral inclusion
bodies were also observed in the gastric epithelial and superficial
chief cells. The low pO2 and mild respiratory acidosis were
interpreted to be due to decreased gas exchange secondary to
the thickening of the alveolar septa and multifocal obliteration
of alveolar lumina.
-
- Toxoplasma gondii and Neospora caninum can be very difficult
to distinguish histologically. In fact, prior to 1988, Neospora
caninum was misdiagnosed as Toxoplasma gondii. However, Neospora
caninum is not a new disease as retrospective studies using monoclonal
antibodies to Neospora caninum on formalin fixed, paraffin embedded
tissue indicate that prior cases, as early as 1957, of Toxoplasma
gondii were actually Neospora caninum. The protozoal organisms
in this case are most likely Toxoplasma gondii as Neospora caninum
tissue cysts are only found in the central nervous system (CNS).
Tissue cysts in this dog were found in the CNS as well as the
lungs, liver, and an adrenal gland. Toxoplasmosis is further
supported, in addition to the extensive extraneural tissue cyst
distribution, by the specific staining of the organisms using
immunohistochemistry with a polyclonal antibody against Toxoplasma
gondii (Biogenex Laboratories - San Ramon, California).
-
- Neospora caninum is often a primary disease in dogs whereas
Toxoplasma gondii typically occurs concurrently with CDV. CDV
is known to cause immunosuppression in the dog. Immunocompetent
dogs can become infected with Toxoplasma gondii and elicit an
immune response which precludes clinical disease. However, in
the face of an immunosuppressive disease such as CDV, the host
immune system can no longer keep the Toxoplasma gondii in check.
It is not known in this case if steroids used to treat this
animal clinically also contributed to this dog's inability to
mount an immune response against Toxoplasma gondii. The corneal
edema may have been vaccine-induced or secondary to the Toxoplasma
gondii, but there were no specific lesions to suggest an etiology.
-

- Case 30-4. Lung. There are many macrophages in alveoli
and expanding alveolar septa. Note syncytial cell (upper right)
and a cell containing tachyzoites (lower left).
 40x
40x
- Case 30-4. Lung. Immunohistochemical staining directed
against Toxoplasma gondii antigens renders zoites dark
red-brown.
-
- AFIP Diagnosis: Lung: Pneumonia, interstitial, necrotizing,
subacute, diffuse, severe, with type 2 pneumocyte hyperplasia,
bronchiolitis, hemorrhage, numerous protozoa, few syncytia cells
and few intracytoplasmic inclusion bodies, toy poodle, canine.
Conference Note: Immunohistochemistry performed at the
AFIP demonstrated the presence of morbilliviral antigen confirming
the diagnosis of canine distemper. Immunohistochemistry for
Toxoplasma gondii was also positive.
-
- The public health significance of toxoplasmosis was discussed
in conference. Human seroprevalence approaches 100% in tropical
climates. In the United States, 25 to 50% of people are antibody-positive.
The vast majority of people infected after birth have no clinical
illness. The most significant forms of human toxoplasmosis are
transplacental infection and infection of immunosuppressed individuals.
Cats are the definitive hosts of Toxoplasma gondii and contaminate
the environment with oocysts; however, there is no correlation
between toxoplasmosis in adults and cat ownership. Herbivores
become infected by consuming oocysts. Most people become infected
by consuming undercooked bradyzoite-containing meat. Most cats
are infected shortly after weaning and shed oocysts for only
a few weeks. Seropositive cats pose little risk to humans since
they are unlikely to shed oocysts. Seronegative cats are of
greater risk because they may become infected and shed oocysts.
-
- Contributor: North Carolina State University, College
of Veterinary Medicine, Department of Microbiology, Pathology,
and Parasitology, 4700 Hillsborough Street, Raleigh, North Carolina
27606.
-
- References:
- 1. Dubey JP: Toxoplasmosis in dogs. Canine Pract 12:7-25,
1985
- 2. Dubey JP, Lindsay DS: Neosporosis. Parasit Today 9:452-458,
1993
- 3. Rhyan J, Dubey JP: Toxoplasmosis in an adult dog with
hepatic necrosis and associated tissue cysts and tachyzoites.
Canine Pract 17:6-10, 1992
- 4. Dubey JP, Lappin MR: Toxoplasmosis and Neosporosis.
In: Infectious Diseases of the Dog and Cat, ed. Greene CE, pp
493-509. WB Saunders Company, Philadelphia, PA, 1998
-
-
- J Scot Estep, DVM
Captain, United States Army
Registry of Veterinary Pathology*
Department of Veterinary Pathology
Armed Forces Institute of Pathology
(202) 782-2615; DSN: 662-2615
Internet: Estep@afip.osd.mil
-
- * The American Veterinary Medical Association and the American
College of Veterinary Pathologists are co-sponsors of the Registry
of Veterinary Pathology. The C.L. Davis Foundation also provides
substantial support for the Registry.
-
- Return to WSC Case Menu

40x
40x